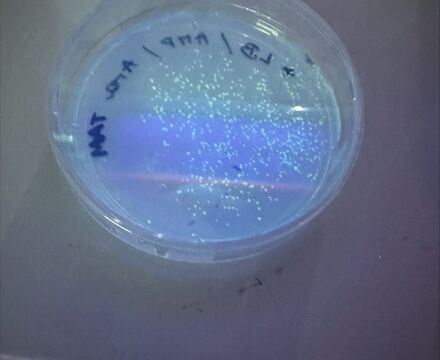
PGLO Photo

- Home
- News & Dates
- News
- From Jellyfish to Genetics
News
From Jellyfish to Genetics
Posted on 20th May 2025Year 12 Students Explore Genetic Engineering in Action
In an exciting hands-on experiment, Year 12 A-Level Biology students brought one of the most important principles of biology - the central dogma - to life. This fundamental concept explains how DNA contains the instructions needed to produce proteins, the molecules that drive nearly all cellular processes.
To explore this idea, students took part in a genetic transformation lab where they altered the genetic material of E. coli bacteria by inserting a gene originally found in jellyfish. Using a plasmid (a small circular piece of DNA) they introduced a gene that encodes Green Fluorescent Protein (GFP) into the bacteria. Once successfully transformed, the modified bacteria began to glow bright green under ultraviolet light, visual confirmation that the gene had been expressed and the protein produced. This same technique is foundational in many real-world applications of genetic engineering, including the production of human insulin in genetically modified bacteria for the treatment of diabetes.
One of the greatest challenges in molecular biology is that so much of what we study is invisible to the naked eye. That’s where GFP makes a difference. First isolated from the jellyfish Aequorea Victoria, GFP has become an essential tool in molecular biology. It is widely used in research to track proteins, making otherwise invisible processes visible through fluorescence. With a simple UV lamp, students were able to observe gene expression in real time, turning abstract textbook concepts into reality.
By conducting this transformation, students not only deepened their understanding of genetic concepts but also developed valuable laboratory skills. They practised techniques used by scientists around the world, gaining practical experience that bridges classroom theory with real scientific investigation.
This practical session didn’t just teach biology, it inspired. Several students expressed how the experience opened their eyes to potential careers in science and biotechnology. As one student commented, “It was amazing to see something we learn in textbooks actually happening in front of us in school.”
Mr Seymour